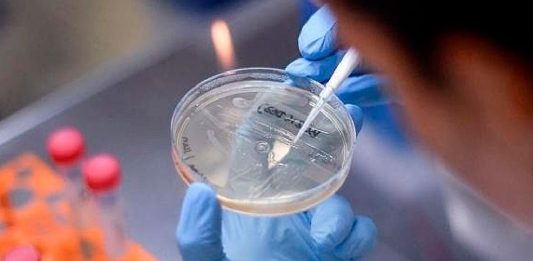

INS: en unas semanas la variante Eris podría aparecer en Perú
“Es cuestión de semanas que la variante Eris aparezca en Perú”, indicó Roger Araujo, médico infectólogo del Instituto Nacional de Salud. Roger Araujo Castillo, médico infectólogo del Instituto Nacional de Salud, indicó que la variante de Omicrón Eg.5 también conocida como Eris está produciendo aumento de casos en los países en donde ha aparecido, por … Sigue leyendo INS: en unas semanas la variante Eris podría aparecer en Perú